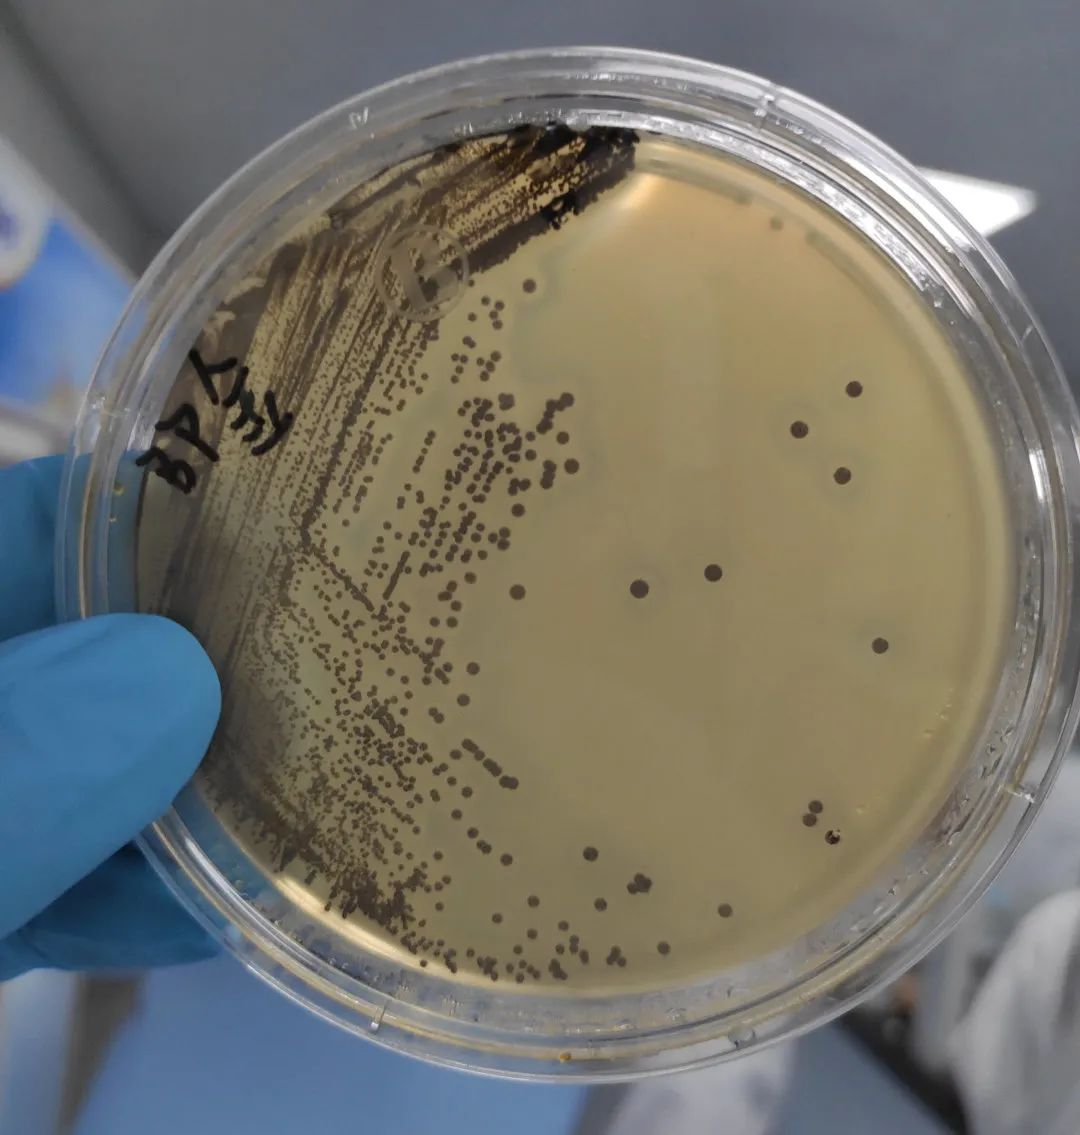
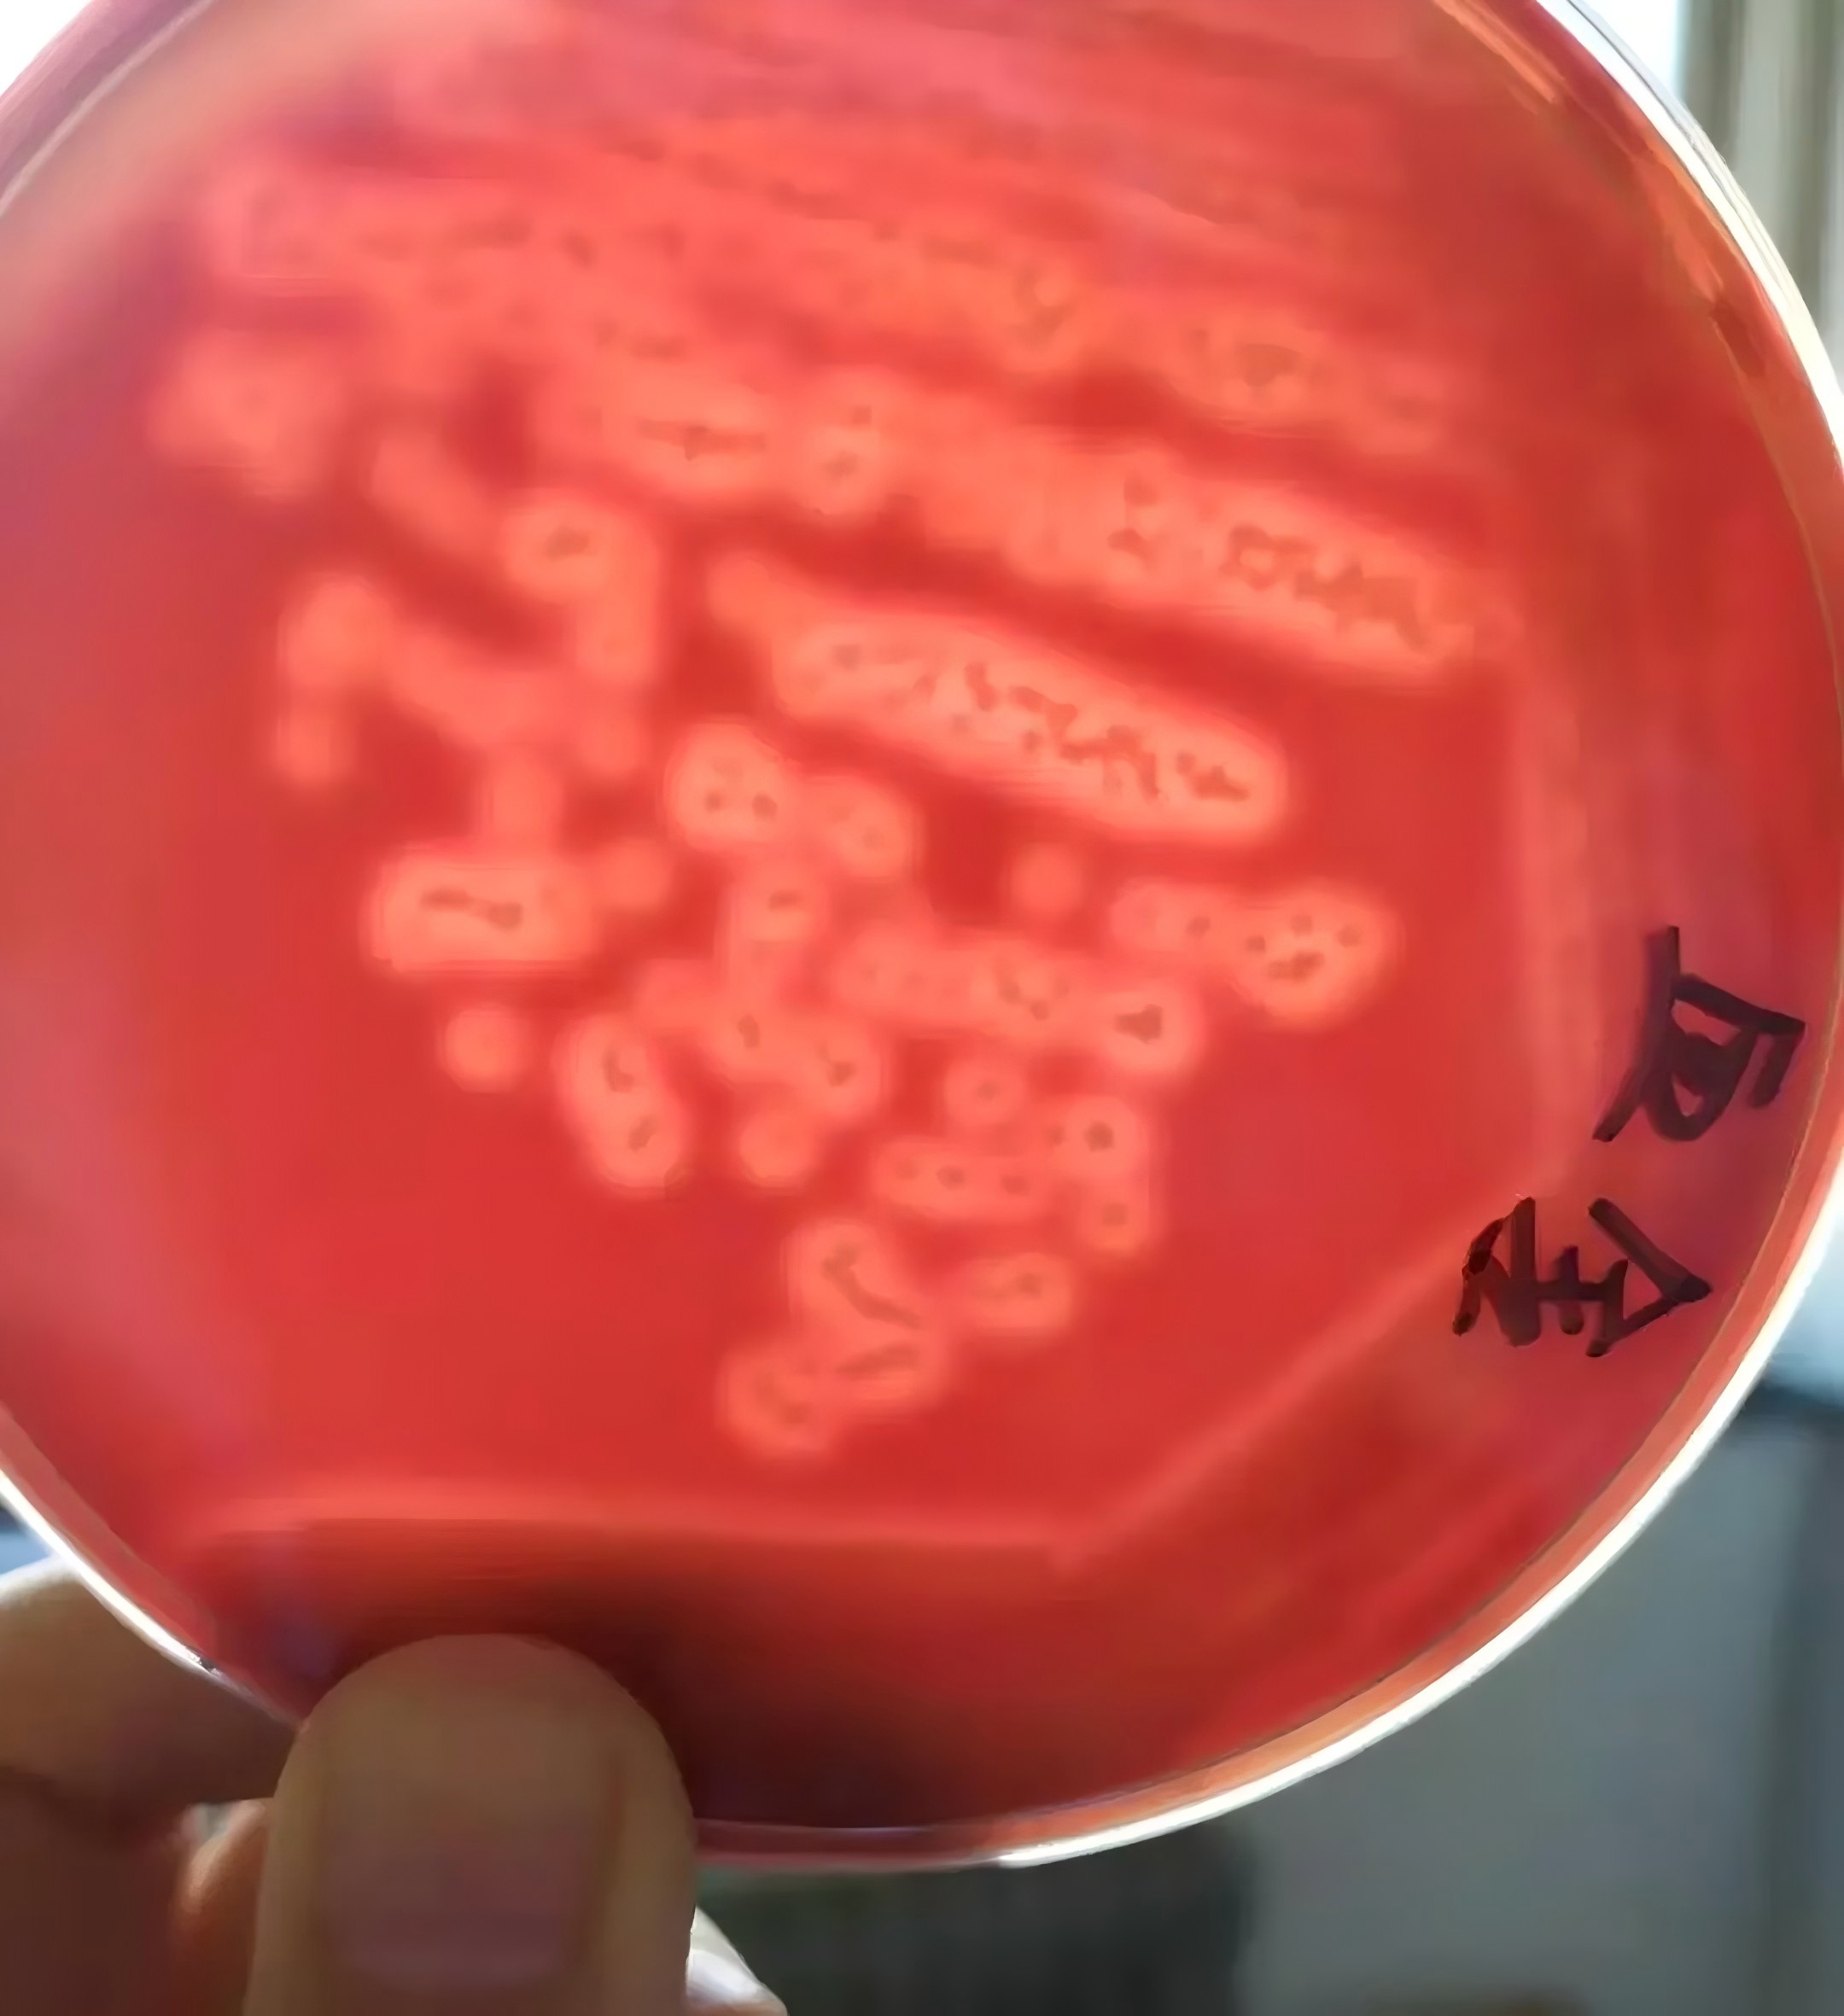
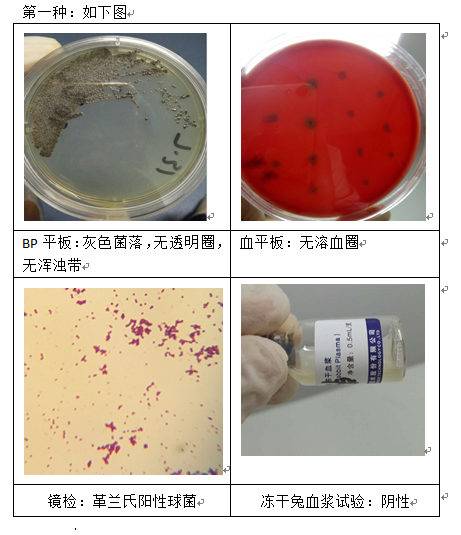
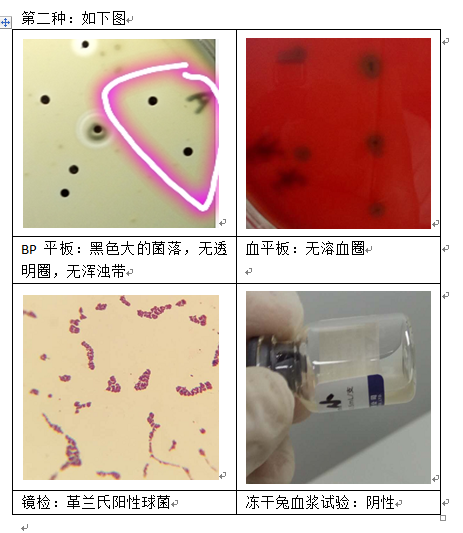
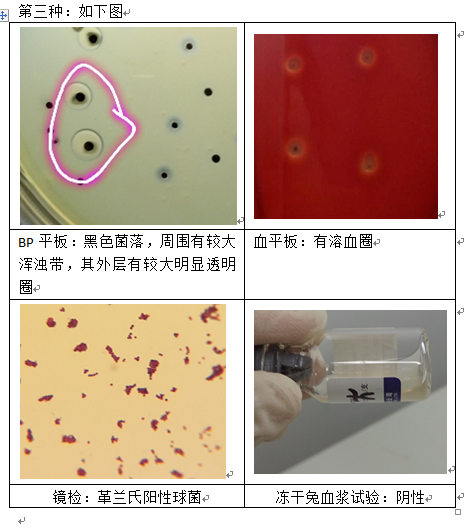
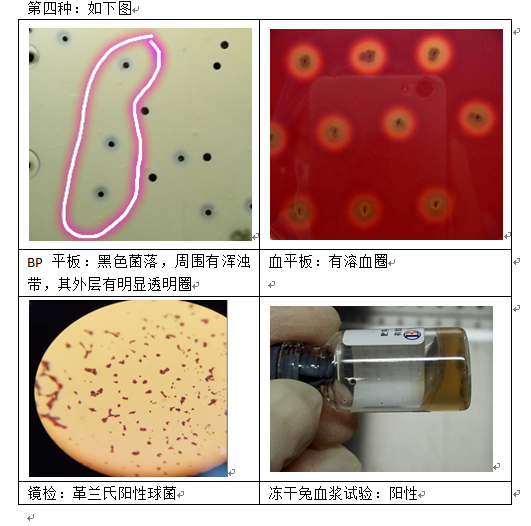
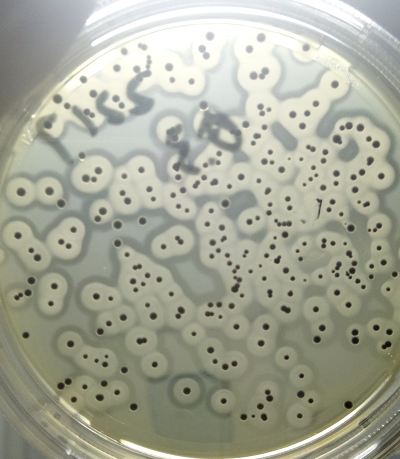

金黃色葡萄球菌菌落在不同培養(yǎng)基上的顏色變化
發(fā)布時(shí)間:2024-10-21 瀏覽次數(shù):2344
金黃色葡萄球菌菌落在不同培養(yǎng)基上的顏色變化可以因其生長(zhǎng)條件、培養(yǎng)基的配方以及菌株本身的特性而有所不同。
一、金黃色葡萄球菌在不同培養(yǎng)基上顏色變化的一種歸納性描述:
1、典型培養(yǎng)基:【?BP瓊脂(Baird-Parker Agar)、?血平板(Blood Agar)?】
① ?BP瓊脂(Baird-Parker Agar):
● 菌落顏色:典型的金黃色葡萄球菌在BP瓊脂上常呈現(xiàn)灰黑色至黑色,且菌落周圍繞以不透明圈(沉淀),其外常有一清晰帶(卵磷脂環(huán))。然而,也有時(shí)金黃色葡萄球菌不顯灰黑色,但其外圍仍有一不透明圈。
● 生長(zhǎng)特點(diǎn):菌落圓形、光滑、凸起、濕潤(rùn),直徑約為2-3mm。
② 血平板(Blood Agar)?:
● 菌落顏色:在血平板上,金黃色葡萄球菌菌落常呈金黃色,有時(shí)也可能為白色。菌落大而突起,圓形,不透明,表面光滑,周圍有溶血圈。
● 生長(zhǎng)特點(diǎn):溶血圈的存在是金黃色葡萄球菌在血平板上的一個(gè)顯著特征,它反映了該菌產(chǎn)生的溶血素對(duì)紅細(xì)胞的破壞作用。
2、其他培養(yǎng)基【?胰酪胨大豆肉湯(Trypticase Soy Broth, TSB)?、顯色培養(yǎng)基等】
① ??胰酪胨大豆肉湯(Trypticase Soy Broth, TSB)?:
● 菌落顏色:在液體培養(yǎng)基如TSB中,金黃色葡萄球菌的生長(zhǎng)表現(xiàn)為培養(yǎng)基的混濁度增加,菌體呈懸浮狀態(tài),無法直接觀察到菌落顏色。但通過觀察培養(yǎng)基的混濁度可以間接判斷其生長(zhǎng)情況。
② 其他顯色培養(yǎng)基?:
● 某些顯色培養(yǎng)基被設(shè)計(jì)用于快速檢測(cè)和鑒定金黃色葡萄球菌。在這些培養(yǎng)基上,金黃色葡萄球菌可能呈現(xiàn)出特定的顏色變化,如黃色暈環(huán)等,這些變化有助于快速識(shí)別和區(qū)分該菌。但具體的顏色變化取決于所使用的培養(yǎng)基種類和配方。
3、金黃色葡萄球菌在甘露醇高鹽瓊脂培養(yǎng)基上典型特征

● 金黃色葡萄球菌顯黃色,其外圍有一黃色的暈環(huán)。
關(guān)于金黃色葡萄球菌在BP平板上的形態(tài)以及后續(xù)生化分析
第一種形態(tài):
第二種形態(tài):
第三種形態(tài):
第四種形態(tài):
一些典型可疑平板圖如下:
![]() | ![]() |
來源:網(wǎng)絡(luò),內(nèi)容版權(quán)歸原作者所有。
說明:文章、視頻、圖片等所有內(nèi)容,僅用于學(xué)習(xí)交流,若有侵權(quán)內(nèi)容及其他涉法內(nèi)容,請(qǐng)及時(shí)聯(lián)系刪除或修改,特此聲明。